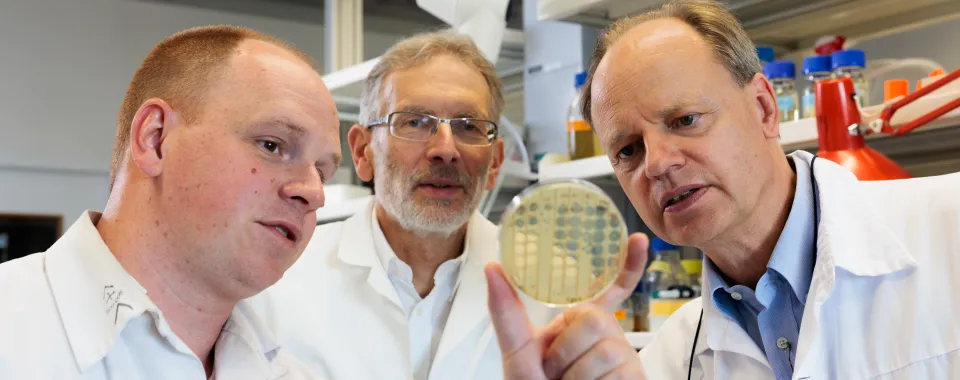
Bacteriophages : Christian van Delden, Thilo Köhler et Alexandre Luscher - Copyright : Jonathan Imhof/ HUG

A multidisciplinary team from the Geneva University Hospitals (HUG) and the University of Geneva (UNIGE) have for the first-time used bacteriophages to successfully treat a patient suffering from an antibiotic-resistant chronic bacterial lung infection. This “premiere” was achieved thanks to a highly personalised, multidisciplinary approach involving the selection of a bacteriophage specific to the patient's multidrug resistant bacteria. While phages are one of the strategies considered to combat the bacterial antibiotic resistance, much work remains to be done to select phages specific to each patient, establish treatment protocols, understand the side effects and avoid the emergence of phage-resistant strains. This unique case of individualised therapy is helping to provide answers. It has been published in the journal Nature Communications.
An unconventional treatment
In this publication, a team from the HUG and the UNIGE used phagotherapy to successfully treat a 41-year-old patient suffering from chronic lung disease caused by a multidrug-resistant strain of the bacterium Pseudomonas aeruginosa. After six months of hospitalisation in the HUG, totally dependent on continuous intravenous antibiotic therapy, and with no prospect of improvement, the patient received an experimental last-resort phage treatment authorised on a compassionate basis. This finally enabled him to leave the hospital, regain his independence and return to work.
Phage therapy is an approach that uses bacteriophages to fight bacterial infections. For bacteria, phages are "natural viruses” targeting specific bacterial strains without being able to infect human cells. Used in combination with antibiotics, they help to overcome antibiotic resistance. Although this strategy is promising, basic scientific and clinical data are still needed to develop treatments that are effective, safe, and approved by the health authorities, which is not yet the case.
A highly individualised therapeutic approach
"Bacteria can develop resistance to both phages and antibiotics. To increase our chances of therapeutic success, it was therefore crucial to select the appropriate phage specific for the bacterial strain infecting the patient prior to phage therapy", stresses Dr Thilo Köhler, research group co-leader in the Department of Microbiology and Molecular Medicine at the UNIGE Faculty of Medicine. To do this, the HUG and UNIGE team first isolated the bacteria from the patient's respiratory secretions, then determined the type of bacteria present, its genetic profile and resistance to both antibiotics and a phage bank. After an intensive but fruitless search of the phage banks at the HUG, the Lausanne University Hospital (CHUV) and the European Phage Centre at the Queen Astrid Military Hospital in Brussels, involving hundreds of different phages, a phage active on the patient's bacteria was finally identified at Yale University in the United States.
Efficacious without adverse effects
The phages were administered by aerosol while intravenous antibiotics were maintained. The patient's improvement was spectacular and without any side effects, confirming the efficacy and safety of the phages. Detailed monitoring of bacteria and phages in the patient’s secretions proved that phage replication was limited to its bacterial target, with no emergence of more resistant or dangerous bacteria. "However, it is important to emphasise that phage therapy is used as a complement to antibiotic therapy and not as a replacement," insists Prof. Christian van Delden, Staff Physician in the Division of Infectious Diseases at the HUG and Full Professor in the Department of Medicine at the UNIGE Faculty of Medicine, before stressing the importance of research into new strategies to combat antibiotic resistance. He highlights the success of the translational approach used: from the patient, through the laboratory, and back to the patient. The Geneva team also warmly recognises the collaboration with the American group who generously provided the phages free of charge. Without them, this life could not have been saved".
Combating antibiotic resistance
Antibiotic resistance is a global health emergency, causing millions of deaths worldwide every year - 1.7 million in 2019 according to the WHO. This scourge is mainly due to the intrinsic properties of bacteria. In nature, as in the human body, they form an ecosystem with their enemies, such as other bacterial species, fungi and bacteriophages. To deal with this, bacteria have the natural ability to evolve rapidly through mutations, enabling them not only to adapt to their environment, but also to evade antibiotics. Prolonged or repeated exposure to antibiotics automatically leads to the selection of resistant bacterial strains. Phage therapy is one of the promising strategies for overcoming this major human health threat.
DOI : 10.1038/s41467-023-39370-z
HUG, Press and Public Relations Service
presse-hug@hug.ch
+41 22 372 37 37
UNIGE, Media Service
media@unige.ch
+41 22 379 77 96